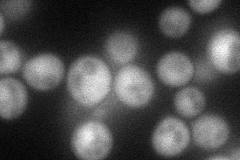
YJL047C
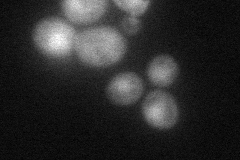
YJL047C

View description
Cullin subunit of a Roc1p-dependent E3 ubiquitin ligase complex with a role in anaphase progression; implicated in Mms22-dependent DNA repair; involved with Mms1p in nonfunctional rRNA decay; modified by the ubiquitin-like protein, Rub1p
Localization:
Intensity:
Fold change:
Significance:
-
C’ GFP library in SD

nucleus22.11 -
N' NOP1pr-GFP in SD
cytosol57.7972 -
N' TEF2pr-mCherry in SD
nucleus29.8779 -
N' NATIVEpr-GFP in SD

cytosol25.4719 -
N' TEF2pr-VC and Cyto-VN in SD

#N/A0 -
C’ GFP library in SD+DTT

nucleus22.51.01No -
C’ GFP library in SD+H2O2

nucleus21.860.98No -
C’ GFP library in Starvation Media

nucleus17.860.8Yes -
C’ GFP library on the background of Pup2-DaMP

nucleus -
C’ GFP library on the background of CCT mutant

nucleus25.2941.14344No
